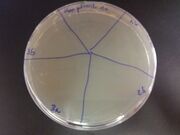
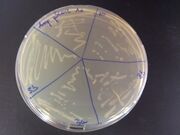

Uploads by Jean Cury
From OpenWetWare
Jump to navigationJump to search
This special page shows all uploaded files.
| Date | Name | Thumbnail | Size | Description |
|---|---|---|---|---|
| 18:04, 24 October 2012 | EmplacementSC.png (file) |  |
504 KB | |
| 17:58, 24 October 2012 | ODSC.png (file) |  |
539 KB | |
| 19:26, 16 October 2012 | Soil 3 JC.png (file) |  |
347 KB | |
| 19:26, 16 October 2012 | Soil 1 2 JC.png (file) |  |
312 KB | |
| 19:56, 20 September 2012 | SGRD190912.jpg (file) |  |
44 KB | |
| 19:55, 20 September 2012 | SGlig190912.jpg (file) |  |
57 KB | |
| 17:35, 20 September 2012 | Gel 20 09 PCRcolo.png (file) |  |
85 KB | |
| 17:16, 20 September 2012 | Gel 20 09 PCR.png (file) |  |
181 KB | |
| 18:30, 19 September 2012 | Gel 19 09 dig.png (file) |  |
143 KB | |
| 17:30, 18 September 2012 | TableRFP supD.jpeg (file) |  |
60 KB | |
| 17:28, 18 September 2012 | TableRFP supD.pdf (file) | 24 KB | ||
| 18:02, 6 September 2012 | 2012-09-06 Amp+Kan MG1655.jpg (file) |  |
2.16 MB | |
| 18:02, 6 September 2012 | 2012-09-06 Kan MG1655.jpg (file) | |
2.03 MB | |
| 18:01, 6 September 2012 | 2012-09-06 Amp MG1655.jpg (file) | |
2.14 MB | |
| 22:24, 2 September 2012 | Gel 02 09 dig.png (file) |  |
68 KB | |
| 10:59, 25 August 2012 | Gel 25 08 dig.png (file) |  |
409 KB | |
| 18:09, 24 August 2012 | Gel 24 08 dig.png (file) |  |
162 KB | |
| 17:41, 25 July 2012 | Gel 25 07 PCR.png (file) |  |
126 KB | |
| 21:12, 22 July 2012 | Gel 21 07 Digestion.png (file) |  |
48 KB | |
| 20:58, 22 July 2012 | Gel 21 07 PCR.png (file) |  |
105 KB | |
| 14:42, 21 July 2012 | Gel 20 07 Digestion.png (file) |  |
155 KB | |
| 10:49, 20 July 2012 | Gel 19 07 Digestion.png (file) |  |
248 KB | |
| 14:53, 16 July 2012 | SupD T1.png (file) | 15 KB | ||
| 12:24, 9 July 2012 | KmR final.png (file) | 16 KB | ||
| 12:23, 9 July 2012 | KmR final.pdf (file) | 27 KB | ||
| 09:30, 9 July 2012 | Semantic.geneious (file) | 194 KB | ||
| 09:27, 9 July 2012 | LacZ S0 1 6.geneious (file) | 16 KB | ||
| 09:13, 9 July 2012 | KmR amber.png (file) | 14 KB | ||
| 13:59, 2 July 2012 | S0 S1 S6.jpg (file) | 71 KB | ||
| 10:32, 29 June 2012 | Algo.png (file) |  |
59 KB | |
| 13:16, 25 June 2012 | Theophuline riboswitch.png (file) |  |
113 KB | |
| 13:13, 25 June 2012 | Theophylin riboswitch.pdf (file) | 260 KB |